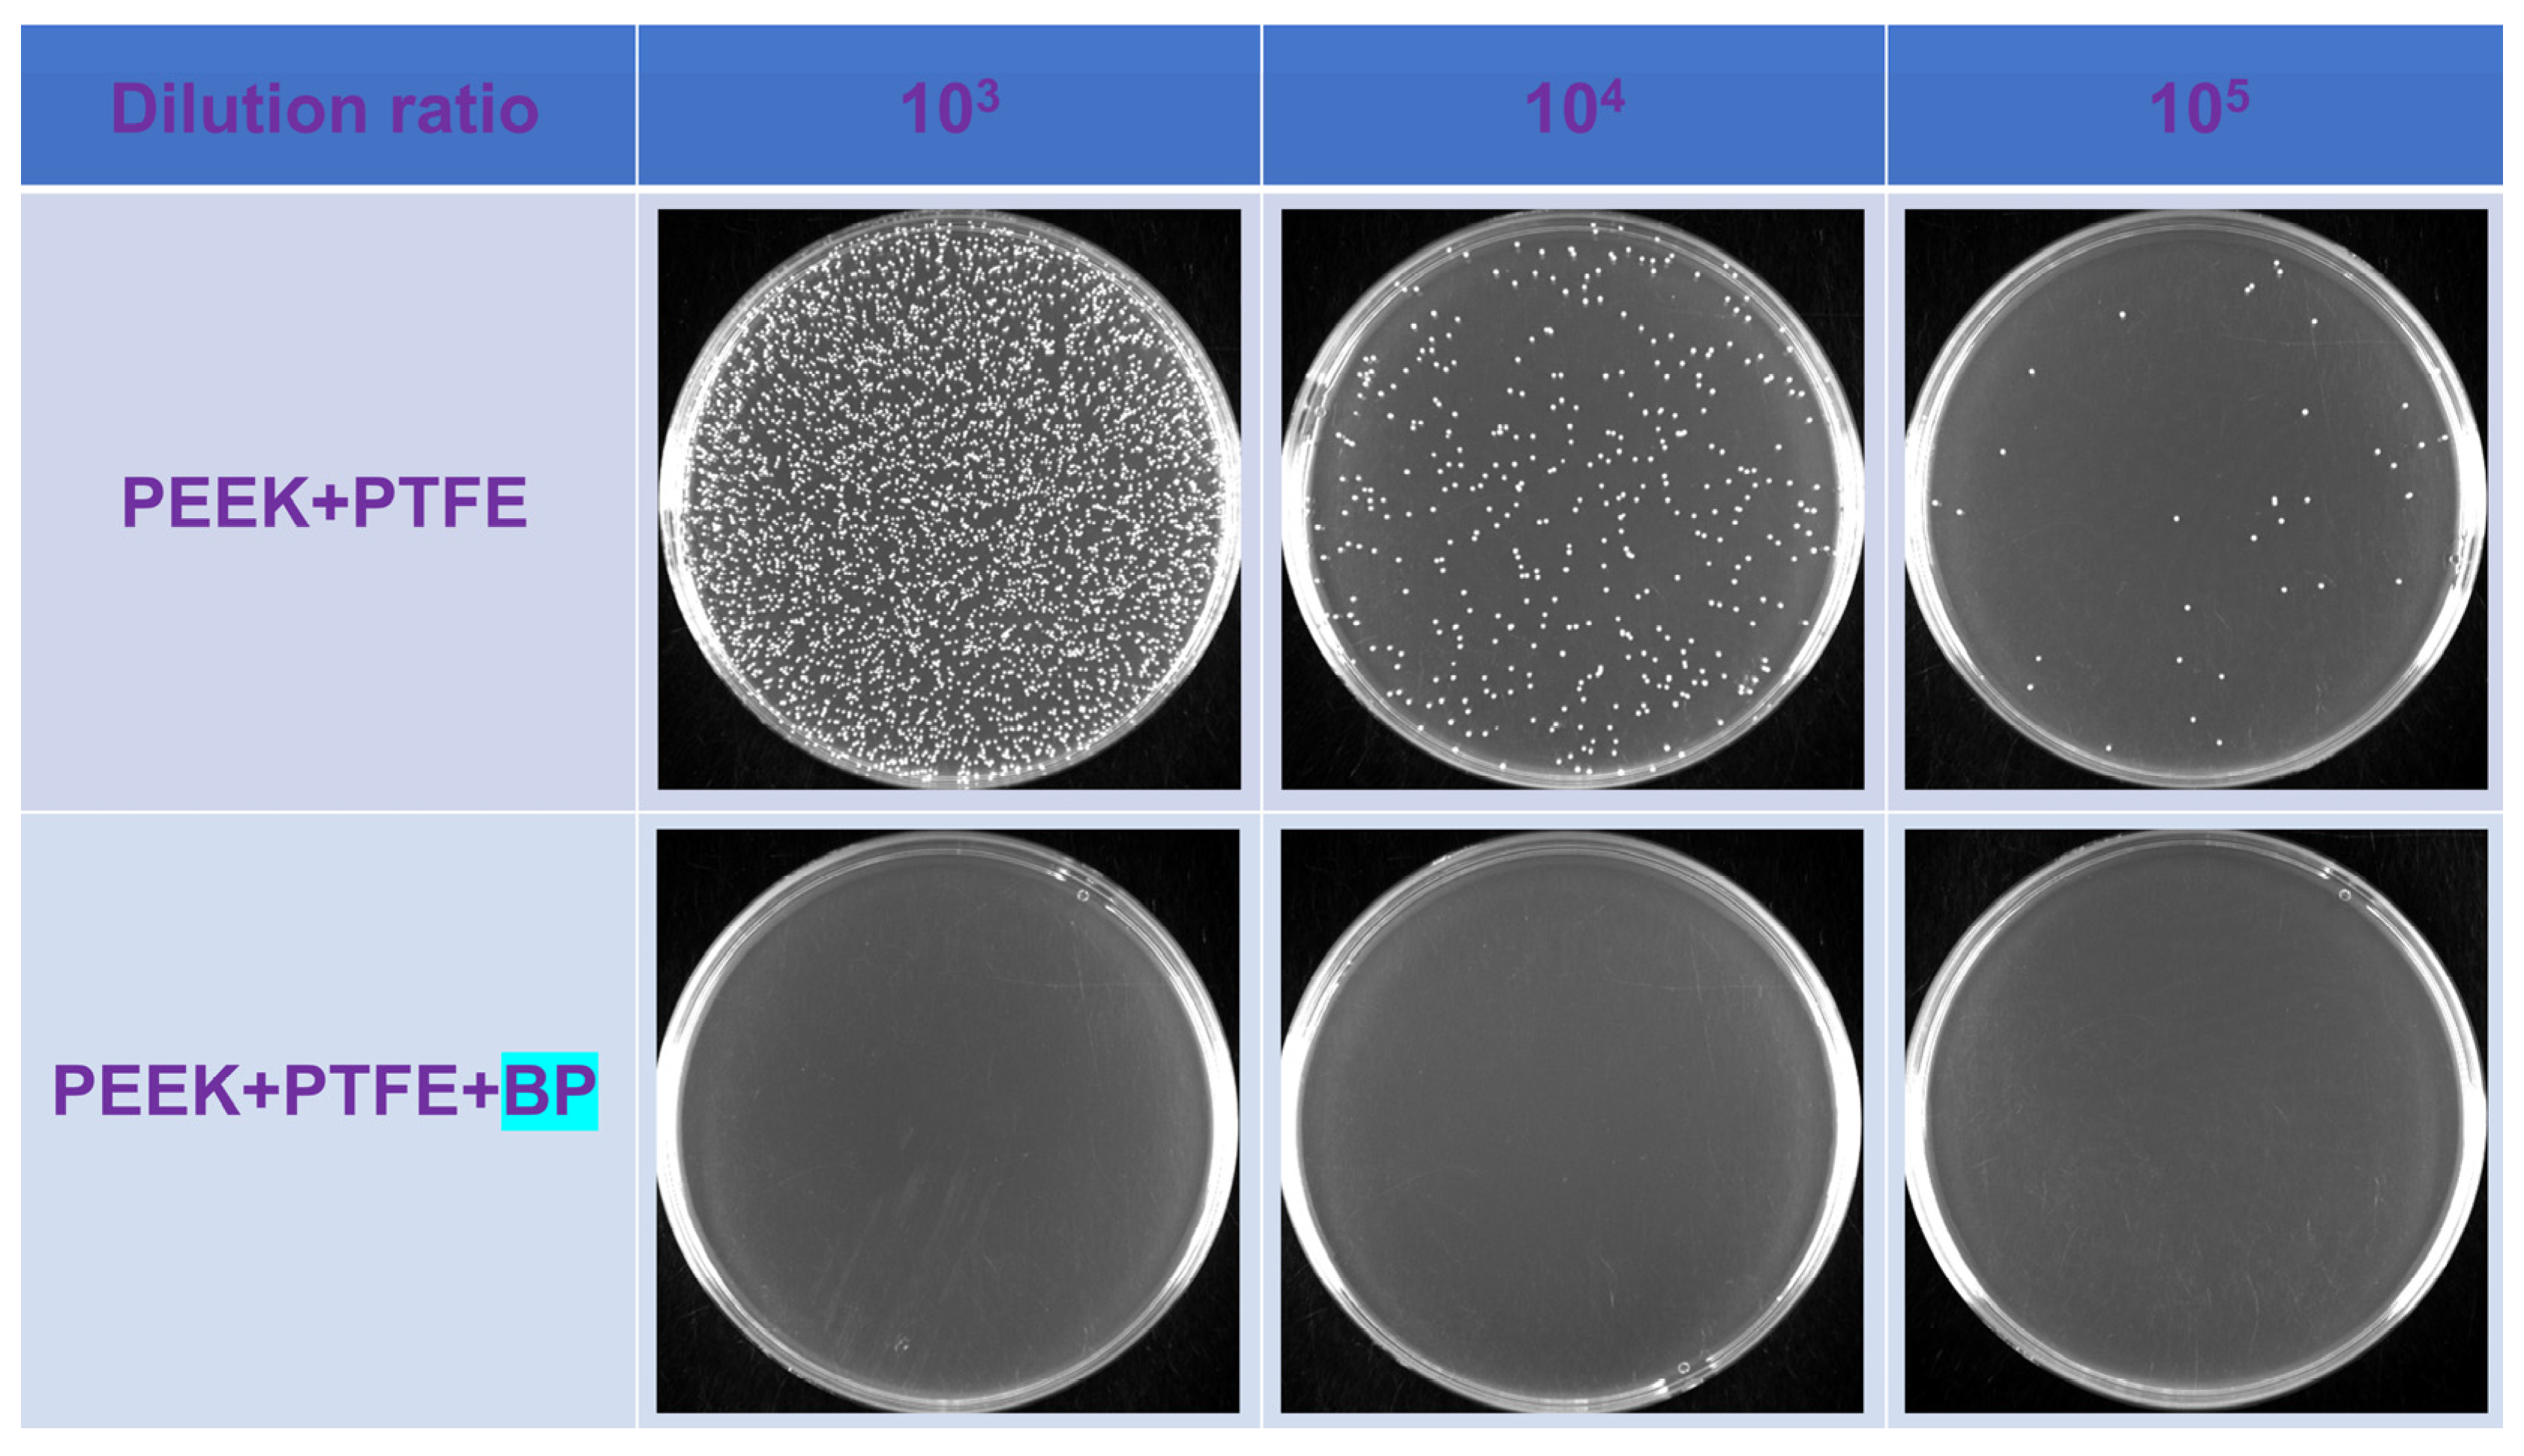

Tribological and Antibacterial Properties of Polyetheretherketone Composites with Black Phosphorus Nanosheets
Abstract
:1. Introduction
2. Materials and Methods
2.1. Materials
2.2. Preparation of Black Phosphorus Nanosheets
2.3. Preparation of PEEK/PTFE/BP Composite
2.4. Frictional Tests and Characterizations
2.4.1. Characterizations of Red Phosphorous (RP) and Black Phosphorous (BP) Nanosheets
2.4.2. Frictional Tests and Characterizations of PEEK Composite Materials
2.5. Antibacterial Experiment by Film Sticking Method
3. Results and Discussion
3.1. Characterizations of RP and BP
3.2. Tribological Properties and Analysis of Composite Materials
3.3. Biological Wettability and Antibacterial Property
4. Conclusions
Author Contributions
Funding
Institutional Review Board Statement
Informed Consent Statement
Data Availability Statement
Conflicts of Interest
References
- Yang, Y.; He, C.; Dianyu, E.; Yang, W.; Qi, F.; Xie, D.; Shen, L.; Peng, S.; Shuai, C. Mg bone implant: Features, developments and perspectives. Mater. Des. 2020, 185, 108259. [Google Scholar] [CrossRef]
- Lee, S.; Yang, F.; Suh, J.; Yang, S.; Lee, Y.; Li, G.; Choe, H.S.; Suslu, A.; Chen, Y.; Ko, C.; et al. Anisotropic in-plane thermal conductivity of black phosphorus nanoribbons at temperatures higher than 100 K. Nat. Commun. 2015, 6, 8573. [Google Scholar] [CrossRef] [PubMed]
- Mailoo, V.J.; Srinivas, V.; Turner, J.; Fraser, W.D. Beware of bone pain with bisphosphonates. BMJ Case Rep. 2019, 12, e225385. [Google Scholar] [CrossRef] [PubMed] [Green Version]
- Hafezi, M.; Qin, L.; Mahmoodi, P.; Dong, M.; Dong, G. In vitro released characteristics of BSA lubricants from agarose hydrogel with tunable mechanical behaviors for artificial joint applications. Biotribology 2021, 28, 100200. [Google Scholar] [CrossRef]
- Lu, H.; Ren, S.; Guo, J.; Li, Y.; Li, J.; Dong, G. Laser textured Co-Cr-Mo alloy stored chitosan/poly (ethylene glycol) composite applied on artificial joints lubrication. Mater. Sci. Eng. C 2017, 78, 239–245. [Google Scholar] [CrossRef] [PubMed]
- Wang, X.; Han, X.; Li, C.; Chen, Z.; Huang, H.; Chen, J.; Wu, C.; Fan, T.; Li, T.; Huang, W.; et al. 2D materials for bone therapy. Adv. Drug Delivery Rev. 2021, 178, 113970. [Google Scholar] [CrossRef] [PubMed]
- Wu, T.; Zhang, X.; Chen, K.; Chen, Q.; Yu, Z.; Feng, C.; Qi, J.; Zhang, D. The antibacterial and wear-resistant nano-ZnO/PEEK composites were constructed by a simple two-step method. J. Mech. Behav. Biomed. Mater. 2021, 126, 104986. [Google Scholar] [CrossRef] [PubMed]
- Monich, P.R.; Henriques, B.; Novaes de Oliveira, A.P.; Souza, J.C.M.; Fredel, M.C. Mechanical and biological behavior of biomedical PEEK matrix composites: A focused review. Mater. Lett. 2016, 185, 593–597. [Google Scholar] [CrossRef]
- Zhao, Y.; Wong, H.M.; Wang, W.; Li, P.; Xu, Z.; Chong, E.Y.; Yan, C.H.; Yeung, K.W.; Chu, P.K. Cytocompatibility, osseointegration, and bioactivity of three-dimensional porous and nanostructured network on polyetheretherketone. Biomaterials 2013, 34, 9264–9277. [Google Scholar] [CrossRef] [PubMed]
- Xin, H.; Liu, R.; Zhang, L.; Jia, J.; He, N.; Gao, S.; Jin, Z. A comparative bio-tribological study of self-mated PEEK and its composites under bovine serum lubrication. Biotribology 2021, 26, 100171. [Google Scholar] [CrossRef]
- Kurtz, S.M.; Devine, J.N. PEEK biomaterials in trauma, orthopedic, and spinal implants. Biomaterials 2007, 28, 4845–4869. [Google Scholar] [CrossRef] [PubMed] [Green Version]
- He, M.; Huang, Y.; Xu, H.; Feng, G.; Liu, L.; Li, Y.; Sun, D.; Zhang, L. Modification of polyetheretherketone implants: From enhancing bone integration to enabling multi-modal therapeutics. Acta Biomater. 2021, 129, 18–32. [Google Scholar] [CrossRef] [PubMed]
- Ma, H.; Suonan, A.; Zhou, J.; Yuan, Q.; Liu, L.; Zhao, X.; Lou, X.; Yang, C.; Li, D.; Zhang, Y.G. PEEK (Polyether-ether-ketone) and its composite materials in orthopedic implantation. Arabian J. Chem. 2021, 14, 102977. [Google Scholar] [CrossRef]
- Zhao, X.; Xiong, D.; Wang, K.; Wang, N. Improved biotribological properties of PEEK by photo-induced graft polymerization of acrylic acid. Mater. Sci. Eng. C 2017, 75, 777–783. [Google Scholar] [CrossRef] [PubMed]
- Wang, L.; He, H.; Yang, X.; Zhang, Y.; Xiong, S.; Wang, C.; Yang, X.; Chen, B.; Wang, Q. Bimetallic ions regulated PEEK of bone implantation for antibacterial and osteogenic activities. Mater. Today Adv. 2021, 12, 100162. [Google Scholar] [CrossRef]
- Zhang, X.; Zhang, Y.; Jin, Z. A review of the bio-tribology of medical devices. Friction 2021, 10, 4–30. [Google Scholar] [CrossRef]
- Ionescu, R.N.; Totan, A.R.; Imre, M.M.; Tancu, A.M.C.; Pantea, M.; Butucescu, M.; Farcasiu, A.T. Prosthetic materials used for implant-supported restorations and their biochemical oral interactions: A narrative review. Materials 2022, 15, 1016. [Google Scholar] [CrossRef] [PubMed]
- Mishra, T.K.; Kumar, A.; Verma, V.; Pandey, K.N.; Kumar, V. PEEK composites reinforced with zirconia nanofiller. Compos. Sci. Technol. 2012, 72, 1627–1631. [Google Scholar] [CrossRef]
- Nakonieczny, D.S.; Kern, F.; Dufner, L.; Antonowicz, M.; Matus, K. Alumina and zirconia-reinforced polyamide PA-12 composites for biomedical additive manufacturing. Materials 2021, 14, 6201. [Google Scholar] [CrossRef] [PubMed]
- Soares, P.M.; Cadore-Rodrigues, A.C.; Souto Borges, A.L.; Valandro, L.F.; Pereira, G.K.R.; Rippe, M.P. Load-bearing capacity under fatigue and FEA analysis of simplified ceramic restorations supported by PEEK or zirconia polycrystals as foundation substrate for implant purposes. J. Mech. Behav. Biomed. Mater. 2021, 123, 104760. [Google Scholar] [CrossRef] [PubMed]
- Belwanshi, M.; Jayaswal, P.; Aherwar, A. Mechanical behaviour investigation of PEEK coated titanium alloys for hip arthroplasty using finite element analysis. Mater. Today Proc. 2021, in press. [Google Scholar] [CrossRef]
- Priester, M.; Muller, W.D.; Beuer, F.; Schmidt, F.; Schwitalla, A.D. Performance of PEEK based telescopic crowns, a comparative study. Dent. Mater. 2021, 37, 1667–1675. [Google Scholar] [CrossRef] [PubMed]
- Thiruchitrambalam, M.; Bubesh Kumar, D.; Shanmugam, D.; Jawaid, M. A review on PEEK composites—manufacturing methods, properties and applications. Mater. Today Proc. 2020, 33, 1085–1092. [Google Scholar] [CrossRef]
- Hoskins, T.J.; Dearn, K.D.; Kukureka, S.N. Mechanical performance of PEEK produced by additive manufacturing. Polym. Test. 2018, 70, 511–519. [Google Scholar] [CrossRef]
- Arif, M.F.; Kumar, S.; Varadarajan, K.M.; Cantwell, W.J. Performance of biocompatible PEEK processed by fused deposition additive manufacturing. Mater. Des. 2018, 146, 249–259. [Google Scholar] [CrossRef]
- Verma, S.; Sharma, N.; Kango, S.; Sharma, S. Developments of PEEK (polyetheretherketone) as a biomedical material: A focused review. Eur. Polym. J. 2021, 147, 110295. [Google Scholar] [CrossRef]
- Zhang, L.; Ren, Y.; Peng, S.; Guo, D.; Wen, S.; Luo, J.; Xie, G. Core-shell nanospheres to achieve ultralow friction polymer nanocomposites with superior mechanical properties. Nanoscale 2019, 11, 8237–8246. [Google Scholar] [CrossRef] [PubMed]
- Bashandeh, K.; Lan, P.; Meyer, J.L.; Polycarpou, A.A. Tribological performance of graphene and PTFE solid lubricants for polymer coatings at elevated temperatures. Tribol. Lett. 2019, 67, 99. [Google Scholar] [CrossRef]
- Shen, M.; Li, B.; Zhang, Z.; Zhao, L.; Xiong, G. Abrasive wear behavior of PTFE for seal applications under abrasive-atmosphere sliding condition. Friction 2019, 8, 755–767. [Google Scholar] [CrossRef] [Green Version]
- Lin, Z.; Yue, H.; Gao, B. Enhancing tribological characteristics of PEEK by using PTFE composite as a sacrificial tribofilm-generating part in a novel dual-pins-on-disk tribometer. Wear 2020, 460–461, 203472. [Google Scholar] [CrossRef]
- Haidar, D.R.; Alam, K.I.; Burris, D.L. Tribological insensitivity of an ultralow-wear poly (etheretherketone)–polytetrafluoroethylene polymer blend to changes in environmental moisture. J. Phys. Chem. C 2018, 122, 5518–5524. [Google Scholar] [CrossRef]
- Peng, S.; Guo, Y.; Xie, G.; Luo, J. Tribological behavior of polytetrafluoroethylene coating reinforced with black phosphorus nanoparticles. Appl. Surf. Sci. 2018, 441, 670–677. [Google Scholar] [CrossRef]
- Lv, Y.; Wang, W.; Xie, G.; Luo, J. Self-lubricating PTFE-based composites with black phosphorus nanosheets. Tribol. Lett. 2018, 66, 61. [Google Scholar] [CrossRef]
- Zeng, Y.; Guo, Z. Synthesis and stabilization of black phosphorus and phosphorene: Recent progress and perspectives. iScience 2021, 24, 103116. [Google Scholar] [CrossRef] [PubMed]
- Basov, D.N.; Fogler, M.M.; Garcia de Abajo, F.J. Polaritons in van der Waals materials. Science 2016, 354, aag1992. [Google Scholar] [CrossRef] [Green Version]
- Sahoo, P.K.; Memaran, S.; Xin, Y.; Balicas, L.; Gutierrez, H.R. One-pot growth of two-dimensional lateral heterostructures via sequential edge-epitaxy. Nature 2018, 553, 63–67. [Google Scholar] [CrossRef] [PubMed] [Green Version]
- Qu, G.; Xia, T.; Zhou, W.; Zhang, X.; Zhang, H.; Hu, L.; Shi, J.; Yu, X.F.; Jiang, G. Property-activity relationship of black phosphorus at the nano-bio interface: From molecules to organisms. Chem. Rev. 2020, 120, 2288–2346. [Google Scholar] [CrossRef] [PubMed]
- Xiong, Z.; Zhang, X.; Zhang, S.; Lei, L.; Ma, W.; Li, D.; Wang, W.; Zhao, Q.; Xing, B. Bacterial toxicity of exfoliated black phosphorus nanosheets. Ecotoxicol. Environ. Saf. 2018, 161, 507–514. [Google Scholar] [CrossRef]
- Naskar, A.; Kim, K.S. Black phosphorus nanomaterials as multi-potent and emerging platforms against bacterial infections. Microb. Pathog. 2019, 137, 103800. [Google Scholar] [CrossRef]
- Shaw, Z.L.; Kuriakose, S.; Cheeseman, S.; Mayes, E.L.H.; Murali, A.; Oo, Z.Y.; Ahmed, T.; Tran, N.; Boyce, K.; Chapman, J.; et al. Broad-spectrum solvent-free layered black phosphorus as a rapid action antimicrobial. ACS Appl. Mater. Interfaces 2021, 13, 17340–17352. [Google Scholar] [CrossRef]
- Anju, S.; Ashtami, J.; Mohanan, P.V. Black phosphorus, a prospective graphene substitute for biomedical applications. Mater. Sci. Eng. C 2019, 97, 978–993. [Google Scholar] [CrossRef] [PubMed]
- Wang, Y.; Lu, X.; Yuan, N.; Ding, J. A novel nickel-copper alternating-deposition coating with excellent tribological and antibacterial property. J. Alloys Compd. 2020, 849, 156222. [Google Scholar] [CrossRef]
- Fellah, M.; Hezil, N.; Touhami, M.Z.; AbdulSamad, M.; Obrosov, A.; Bokov, D.O.; Marchenko, E.; Montagne, A.; Alain, I.; Alhussein, A. Structural, tribological and antibacterial properties of (α + β) based ti-alloys for biomedical applications. J. Mater. Res. Technol. 2020, 9, 14061–14074. [Google Scholar] [CrossRef]
- Yu, D.; Miao, K.; Li, Y.; Bao, X.; Hu, M.; Zhang, K. Sputter-deposited TaCuN films: Structure, tribological and biomedical properties. Appl. Surf. Sci. 2021, 567, 150796. [Google Scholar] [CrossRef]
- Xu, J.; Ji, M.; Li, L.; Wu, Y.; Yu, Q.; Chen, M. Improving wettability, antibacterial and tribological behaviors of zirconia ceramics through surface texturing. Ceram. Int. 2022, 48, 3702–3710. [Google Scholar] [CrossRef]
- Qin, W.; Ma, J.; Liang, Q.; Li, J.; Tang, B. Tribological, cytotoxicity and antibacterial properties of graphene oxide/carbon fibers/polyetheretherketone composite coatings on Ti-6Al-4V alloy as orthopedic/dental implants. J. Mech. Behav. Biomed. Mater. 2021, 122, 104659. [Google Scholar] [CrossRef] [PubMed]
- Zhang, S.; Qin, Z.; Hou, Z.; Ye, J.; Xu, Z.; Qian, Y. Large-scale preparation of black phosphorus by molten salt method for energy storage. Mater. Chem. Phys. 2022, 1, 1–5. [Google Scholar] [CrossRef]
- Liu, W.; Tao, Z.; Wang, D.; Liu, Q.; Wu, H.; Lan, S.; Dong, A. Engineering a black phosphorus-based magnetic nanosystem armed with antibacterial N-halamine polymer for recyclable blood disinfection. Chem. Eng. J. 2021, 415, 128888. [Google Scholar] [CrossRef]
- Huang, S.; Xu, S.; Hu, Y.; Zhao, X.; Chang, L.; Chen, Z.; Mei, X. Preparation of NIR-responsive, ROS-generating and antibacterial black phosphorus quantum dots for promoting the MRSA-infected wound healing in diabetic rats. Acta Biomater. 2022, 137, 199–217. [Google Scholar] [CrossRef] [PubMed]
- Luo, S.; Liu, R.; Zhang, X.; Chen, R.; Yan, M.; Huang, K.; Sun, J.; Wang, R.; Wang, J. Mechanism investigation for ultra-efficient photocatalytic water disinfection based on rational design of indirect Z-scheme heterojunction black phosphorus QDs/Cu2O nanoparticles. J. Hazard. Mater. 2022, 424, 127281. [Google Scholar] [CrossRef]
- Huang, B.; Tan, L.; Liu, X.; Li, J.; Wu, S. A facile fabrication of novel stuff with antibacterial property and osteogenic promotion utilizing red phosphorus and near-infrared light. Bioact. Mater. 2019, 4, 17–21. [Google Scholar] [CrossRef] [PubMed]

| Serial Number | Concentration of the Colon (CFU/mL) | Antibacterial Rate (%) | |
|---|---|---|---|
| Control Group | Experimental Group | ||
| 1 | 3.4 × 108 | <104 | 99.9 |
| 2 | 5.8 × 109 | <104 | 99.9 |
| 3 | 1.5 × 109 | <104 | 99.9 |
Publisher’s Note: MDPI stays neutral with regard to jurisdictional claims in published maps and institutional affiliations. |
© 2022 by the authors. Licensee MDPI, Basel, Switzerland. This article is an open access article distributed under the terms and conditions of the Creative Commons Attribution (CC BY) license (https://creativecommons.org/licenses/by/4.0/).
Share and Cite
Sun, X.; Yu, C.; Zhang, L.; Cao, J.; Kaleli, E.H.; Xie, G. Tribological and Antibacterial Properties of Polyetheretherketone Composites with Black Phosphorus Nanosheets. Polymers 2022, 14, 1242. https://doi.org/10.3390/polym14061242
Sun X, Yu C, Zhang L, Cao J, Kaleli EH, Xie G. Tribological and Antibacterial Properties of Polyetheretherketone Composites with Black Phosphorus Nanosheets. Polymers. 2022; 14(6):1242. https://doi.org/10.3390/polym14061242
Chicago/Turabian StyleSun, Xuhui, Chengcheng Yu, Lin Zhang, Jingcao Cao, Emrullah Hakan Kaleli, and Guoxin Xie. 2022. "Tribological and Antibacterial Properties of Polyetheretherketone Composites with Black Phosphorus Nanosheets" Polymers 14, no. 6: 1242. https://doi.org/10.3390/polym14061242
APA StyleSun, X., Yu, C., Zhang, L., Cao, J., Kaleli, E. H., & Xie, G. (2022). Tribological and Antibacterial Properties of Polyetheretherketone Composites with Black Phosphorus Nanosheets. Polymers, 14(6), 1242. https://doi.org/10.3390/polym14061242

